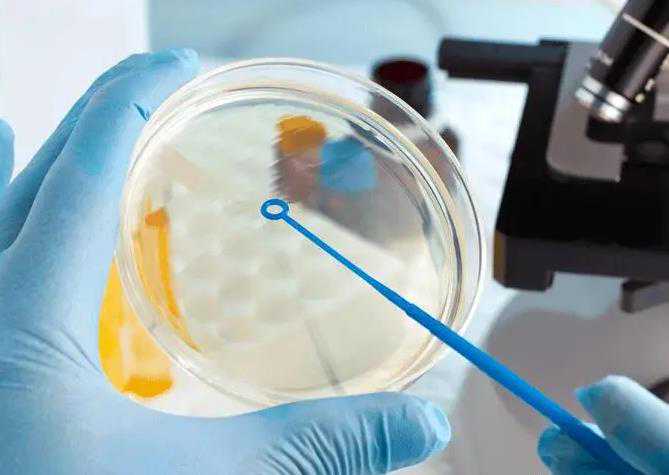
天津供卵代怀男孩，天津做精液检查哪家医院好 天津精子检查费用多少

天津进行精液检查和精子质量分析是评估男性生育能力的重要手段。选择一家合适的医院进行检查,不仅能确保结果的准确性,还能为后续的治疗提供科学依据。
一、天津做精液检查的医院推荐
1. 天津医科大学总医院:作为天津市的一所三级甲等综合医院,天津医科大学总医院拥有先进的设备和技术力量,能够提供高质量的医疗服务。其泌尿外科或生殖医学中心可开展精液质量分析项目,检查结果准确可靠。
2. 天津市中心妇产科医院:该医院专注于妇女、儿童健康服务,同时也为男性提供精液质量分析服务。医院拥有专业的男科医生团队和完备的实验室设施,确保了检测结果的准确性。
3. 天津市第一中心医院:这是一所集医疗、教学与科研为一体的综合性三级甲等医院,设有泌尿外科,可开展精液质量分析项目。医院拥有一支经验丰富的专家队伍,在男性不育诊治方面积累了丰富的临床经验。
4. 天津市肿瘤医院:虽然是一家肿瘤专科医院,但该院也提供精液质量分析服务。其具备完善的生殖医学研究平台及技术优势,能够为患者提供全面的生育咨询及诊疗方案。
5. 武警特色医学中心:该医院设有泌尿外科,可对精液质量进行分析。医院秉承“以患者为中心”的服务理念,致力于打造温馨舒适的就医环境。
6. 天津人民医院:天津人民医院拥有一支高素质、专业化的医护团队,在检查精子质量方面拥有丰富的经验,且检查设备先进,技术精湛,可以为患者提供完善的检查服务。
二、天津精子检查费用
天津精子检查的费用通常在100-300元之间,具体费用可能因医院级别、检查项目以及患者的具体情况而有所差异。一般来说,精液常规检查是最基本的检查项目,费用相对较低。如果需要进行更全面的检查,如精子DNA片段化、遗传检测等,费用可能会相应增加。
天津有多家医院可以进行精液检查和精子质量分析,且费用相对合理。在选择医院时,建议患者根据自己的实际情况和需求选择合适的医院进行检查。同时,为了确保检查结果的准确性,建议患者在检查前避免吸烟、饮酒等不良生活习惯,并保持良好的作息和饮食习惯。
标签:
返回列表Copyright © 2002-2030 艾尚鑫谷试管公司 艾尚鑫谷试管公司